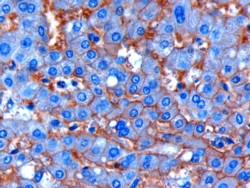

> Antigen, Antibodies, ELISA, Western Blot > Primary Antibody > Polyclonal Antibodies > Goat Anti-ENPP1 / PC1 AntibodyBrand |
Leading Biology | Catalog Number |
AMM04968G |
Product Type |
Polyclonal Antibodies | Field of Research |
|
Product Overview |
We constantly strive to ensure we provide our customers with the best antibodies. As a result of this work we offer this antibody in purified format.
We are in the process of updating our datasheets. If you have any questions regarding this update, please feel free to contact our technical support team.
This product is a high quality Goat Anti-ENPP1 / PC1 antibody.
|
||
Molecular Weight |
104924 Da
|
||
Cellular Localization |
Antigen Cellular Localization:
Cell membrane; Single-pass type II membrane protein. Basolateral cell membrane; Single-pass type II membrane protein. Secreted. Note=The proteolytically processed form is secreted (By similarity). Targeted to the basolateral membrane in polarized epithelial cells and in hepatocytes, and to matrix vesicles in osteoblasts. In bile duct cells and cancer cells, located to the apical cytoplasmic side
|
||
Host |
Goat
|
||
Species Reactivity |
Human
|
||
Isotype |
IgG
|
||
Symbol |
M6S1, NPPS, PC1, PDNP1
|
||
GeneID |
|||
UniProt ID |
|||
Function |
By generating PPi, plays a role in regulating pyrophosphate levels, and functions in bone mineralization and soft tissue calcification. PPi inhibits mineralization by binding to nascent hydroxyapatite (HA) crystals, thereby preventing further growth of these crystals. Preferentially hydrolyzes ATP, but can also hydrolyze other nucleoside 5' triphosphates such as GTP, CTP, TTP and UTP to their corresponding monophosphates with release of pyrophosphate and diadenosine polyphosphates, and also 3',5'-cAMP to AMP. May also be involved in the regulation of the availability of nucleotide sugars in the endoplasmic reticulum and Golgi, and the regulation of purinergic signaling. Appears to modulate insulin sensitivity and function.
|
||
Summary |
This gene is a member of the ecto-nucleotide pyrophosphatase/phosphodiesterase (ENPP) family. The encoded protein is a type II transmembrane glycoprotein comprising two identical disulfide-bonded subunits. This protein has broad specificity and cleaves a variety of substrates, including phosphodiester bonds of nucleotides and nucleotide sugars and pyrophosphate bonds of nucleotides and nucleotide sugars. This protein may function to hydrolyze nucleoside 5' triphosphates to their corresponding monophosphates and may also hydrolyze diadenosine polyphosphates. Mutations in this gene have been associated with 'idiopathic' infantile arterial calcification, ossification of the posterior longitudinal ligament of the spine (OPLL), and insulin resistance.
|
||
Form |
0.5 mg IgG/ml in Tris saline (20mM Tris pH7.3, 150mM NaCl), 0.02% sodium azide, with 0.5% bovine serum albumin |
||
Storage & Stability |
Store at +4°C short term. For long-term storage, aliquot and store at -20°C or below. Stable for 12 months at -20°C. Avoid repeated freeze-thaw cycles.
|
||
Applications |
WB, IHC, E
|
||
Synonyms |
Ectonucleotide pyrophosphatase/phosphodiesterase family member 1, E-NPP 1, Membrane component chromosome 6 surface marker 1, Phosphodiesterase I/nucleotide pyrophosphatase 1, Plasma-cell membrane glycoprotein PC-1, Alkaline phosphodiesterase I, 3.1.4.1, Nucleotide pyrophosphatase, NPPase, 3.6.1.9, ENPP1, M6S1, NPPS, PC1, PDNP1
|
||
Images |

HEK293 overexpressing Human ENPP1 (RC209222) and probed with AMM04968G (mock transfection in first lane), tested by Origene.
AMM04968G (1 μg/ml) staining of paraffin embedded Human Liver. Microwaved antigen retrieval with citrate buffer pH 6, HRP-staining. |
||
Specification |
|||
Quantity |
|
||
| Select | Brand | Catalog No. | Product Name | Pack Size | Type | Field of Research | Specification | Quantity | Price(USD) | |
| 1 | Leading Biology | APR03440G | ITGA11 Antibody (N-term) | 100 μl | Polyclonal Antibodies |
|
$495.00 | Add Ask | ||
| 2 | Leading Biology | APR04537G | CMIP Antibody (C-term) | 100 μl | Polyclonal Antibodies |
|
$495.00 | Add Ask | ||
| 3 | Leading Biology | APR12422G | Human H4 Histamine Receptor (extracellular) Antibody | 50 μl | Polyclonal Antibodies |
|
$695.00 | Add Ask | ||
| 4 | Leading Biology | APR03844G | UBE2W Antibody (C-term) | 100 μl | Polyclonal Antibodies |
|
$495.00 | Add Ask | ||
| 5 | Leading Biology | APR04349G | HECTD2 Antibody (N-term) | 100 μl | Polyclonal Antibodies |
|
$495.00 | Add Ask | ||
| 6 | Leading Biology | APR03502G | IGHG1 Antibody (Center) | 100 μl | Polyclonal Antibodies |
|
$495.00 | Add Ask |
 Leading Biology Inc.
2600 Hilltop DR, Building G, B Suite C138
Richmond, CA, 94806
Tel: 1-661-524(LBI)-0262
Email: info@leadingbiology.com
Leading Biology Inc.
2600 Hilltop DR, Building G, B Suite C138
Richmond, CA, 94806
Tel: 1-661-524(LBI)-0262
Email: info@leadingbiology.com
Complete this form and click send to ask us a question, request a quote or simply say hello.

You have 0 item in your cart

You have 0 item in your inquiry list
